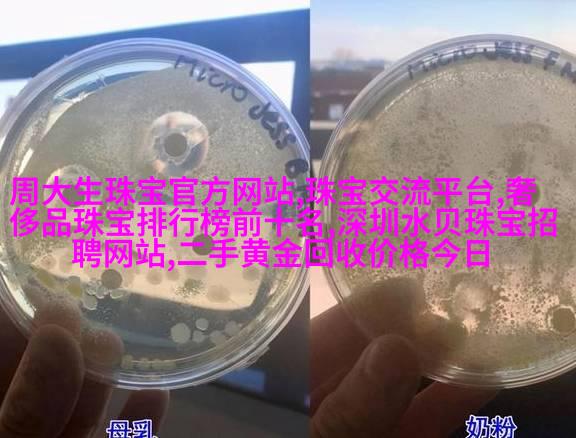

庾澄庆文学与文化的交响乐师
文学创作的探索者

庾澄庆作为一名小说家,其文学创作充满了对传统文化的深刻理解和创新探索。他的作品往往融合了中国传统美术、音乐等元素,与现代文艺风格相结合,展现出独特的艺术魅力。
文化遗产的继承者

在庾澄庆的心中,文化遗产是连接过去与未来的桥梁。他在其作品中不仅继承了中国古典文学的精髓,还通过对现实生活细节的观察和描绘,将历史与当代紧密地联系起来,为读者提供了一种新的文化体验。
语言艺术的大师

庾澄庆擅长运用语言技巧,使得他的每一个句子都如同一首诗一般生动流畅。他的笔下常见于丰富多彩的情感表达,以及对人性的深刻剖析,这些都使得他成为语言艺术领域的一位杰出代表。
故事叙述技巧高手
作为一名优秀的小说家,庾澄庆在故事叙述上有着非凡的手法。他善于构建紧张刺激的情节,同时又能将情感引导至高潮,让读者在阅读过程中经历各种情绪波动,从而提升阅读体验。
文学批评家的视角

不仅是小说家,庾澄庆还是一位深具洞察力的文学批评家。在他看来,每一次文学创作都是对于社会、历史、文化的一次反思与解读。因此,他在作品分析时总能从不同的角度提出独到的见解,为广大读者提供宝贵的心智食粮。
人文关怀者的精神光芒
最终,庾澄庆所追求的是一种超越个人成就的人文关怀。在他的心目中,每个人的生命都值得尊重和爱护,他倡导通过文字去触摸人心,不仅要讲述故事,更要传递正面的价值观念和人生哲理。



